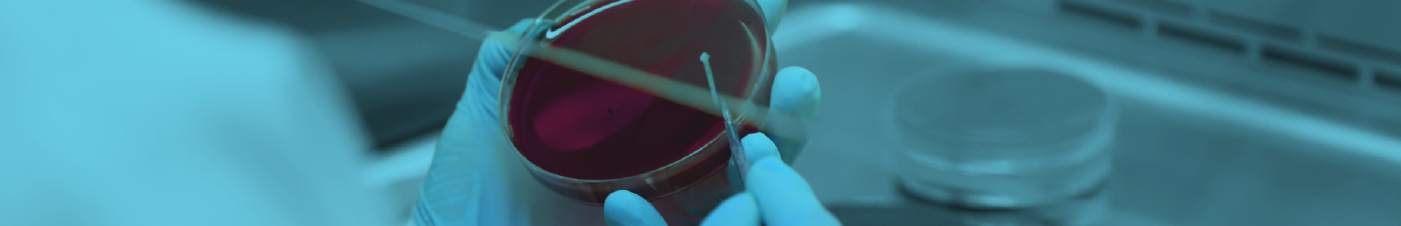
Microlab Industrial

Análisis industriales confiables para cumplimiento de normas sanitarias y ambientales.

Ofrecemos ensayos de laboratorio respaldados por métodos oficiales nacionales e internacionales, orientados a:
Nuestros análisis abarcan agua, alimentos, insumos, procesos, producto terminado y residuos. Brindamos a nuestros clientes herramientas para operar con seguridad, responsabilidad y excelencia técnica.
Nuestra visión es ser un agente de cambio positivo, promoviendo una industria más consciente y sustentable, y colaborando activamente en la construcción de una comunidad más saludable y un más habitable para las generaciones futuras.
En un entorno global caracterizado por continuas transformaciones y crecientes desafíos, adoptar una conducta de responsabilidad social es un pilar estratégico para garantizar su sostenibilidad a largo plazo. Nos adherimos voluntariamente a prácticas y lineamientos que refuerzan una cultura organizacional comprometida con el presente y el futuro de nuestras comunidades, nuestros clientes y de nuestro planeta.
Como organización consciente de su rol en la sociedad, asumimos el compromiso de alinear nuestras operaciones con principios que promueven el respeto por los derechos humanos, la protección del medio ambiente, la transparencia, la equidad y el desarrollo comunitario.
CONTACTA A NUESTROS
AGENTES DE VENTAS

